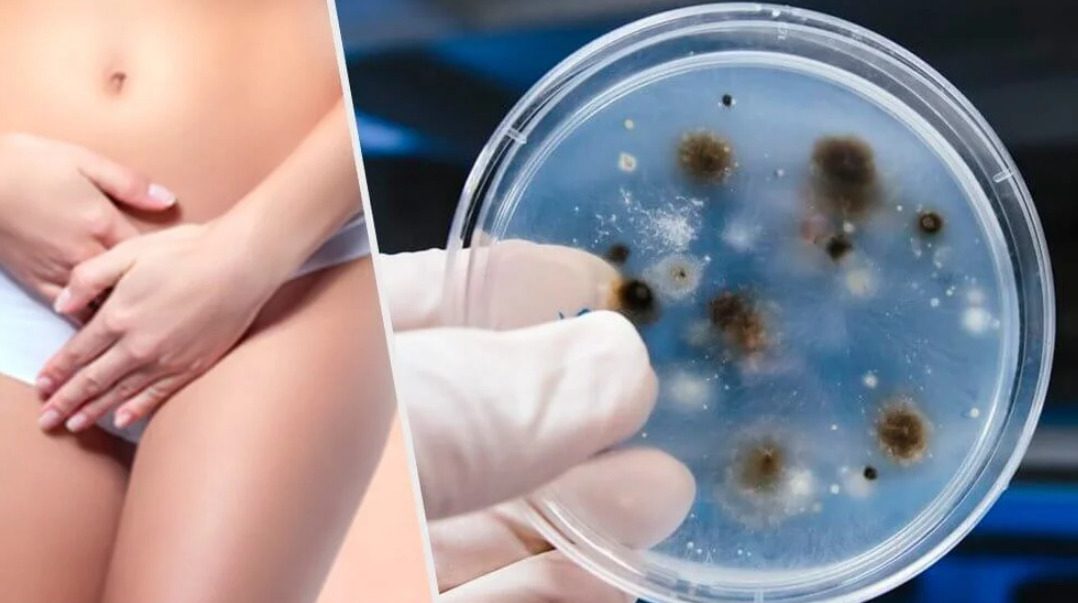

여성 질 건강 유산균 닥터 페미퓨어캡슐 성분 및 효능부터 가격 정리
- 건강 data/영양과 효능
- 2021. 3. 2.
오늘은 든실이네 586번째 건강 이야기 "여성 질 건강 유산균 닥터 페미퓨어캡슐" 관하여 설명을 드리고자 합니다. 유산균은 친근하면서도 종류가 다양하여 다소 생소하기도 하는 영양성분에 해당합니다. 더욱이, 최근 몇 년전부터 건강프로그램 및 TV 홈쇼핑 방송 등을 통해 소개된 여성 질 건강 유산균에 대해 관심은 존재하나, 제대로 숙지하고 있는 분들이 그리 많지 않습니다. 프로바이오틱스 유산균 중에서도 여성 질 건강 유산균의 경우, 빠르면 30대 나이부터 주로, 40대 및 50대 이상 중년 여성분들에게 선호되는 경향이 존재합니다. 그 이유는 노화와 갱년기, 면역력 저하 등 복합적으로 작용하고 있으며, 이번 포스트에서는 이러한 유산균 제품 중 한가지로서 여성 질 건강 유산균 닥터 페미퓨어캡슐 성분 및 효능부터 가격 정리에 대해 자세히 알아보겠습니다.

여성 질 건강 유산균 닥터 페미퓨어캡슐 성분 및 효능에 대해 궁금합니다
- 성분 및 효능에 대해 자세히 알아보기 전에 먼저, 구체적으로 어떠한 제품인지 궁금해하실 수 있습니다.
- 닥터 페미퓨어캡슐이란 국내 건강기능식품 제조회사 중 하나인 주식회사 메디오젠에서 출시한 프로바이오틱스 유산균 영양제를 의미합니다.

- 비교적 복용 편의성이 우수한 물과 함께 복용이 가능한 캡슐 형태로 제조되어, 나이가 있는 중년 분들도 선호하는 형태이기도 합니다.
- 물론, 복용법과 무관하게 제품 효능은 핵심 성분으로부터 비롯되며, 면역력 관리부터 더 나아가, 여성 질 건강 및 갱년기 증상 예방에 초점을 두고 있습니다.
- 서론에서 잠시 언급했듯이, 빠르면 30대 나이부터 주로, 40대 및 50대 이상 중년 분들 중심으로 최근 몇 년전부터, 질 건강 유산균에 대해 관심이 증가하고 있습니다.
- 그 이유는 여성이라면 누구가 노화로 인한 호르몬 변화가 찾아오는 갱년기를 겪게 되며, 질 건강에 민감하지 않을 수 없습니다.
- 여성갱년기 시, 여성호르몬인 에스트로겐(Estrogen) 감소로 인해 면역력 저하뿐만 아니라, 질 건조증 및 유익균 감소로 인한 질염이 발생할 가능성이 증가하게 됩니다.
- 이러한 이유로, 의료 전문가들은 30대의 젊은 연령부터 40대 및 50대 이상 중년 여성분들까지 면역력 개선부터 더 나아가, 갱년기 및 질 건강 개선 목적으로 유산균 복용을 권고하고 있습니다.
- 오늘의 주제이기도 하는 여성 질 건강 유산균 닥터 페미퓨어캡슐 제품 또한, 이러한 효능에 초점을 둔 프로바이오틱스 유산균 제품 중 한가지에 해당하는 점 참고하셨으면 하는 바람입니다.
- 구체적인 닥터 페미퓨어캡슐 효능은 핵심 성분으로서 3종의 혼합 유산균으로부터 비롯됩니다.

- 즉, 건강한 한국 여성의 질 세포에서 분리한 균주로서 MG989, MG901, MG242 명칭의 다소 생소할 수 있는 균주로부터 효능에 관여하고 있습니다.
- 체내 복용 시, 위산과 담즙으로부터 사멸률을 최소화한 후, 소화기관을 통과하여 항문에서 회음부를 거쳐 질 내 부에 정착하여, 질 내 유익균 증식 및 유해균 억제하는 역할을 합니다.
- 그로 인해, 질 분비물 및 질 소양감(가려움증)을 감소시키고, 더 나아가 중년 여성의 갱년기성 질염 예방에 효과적으로 작용합니다.
- 또한, 유산균의 공통적인 효능으로서, 체내 면역력의 70%를 담당하는 장 건강을 개선하여 면역력 증진에 도움이 됩니다.
- 이처럼, 성분 및 효능에서 숙지할 수 있듯이 프로바이오틱스 유산균 제품마다 각기 다른 균주로 인해,
- 효능 부분에서 다소 차이가 있는 만큼, 면역력 개선부터 더 나아가, 다이어트 및 근본적인 여성 질 건강 및 갱년기 증상 예방 목적으로서 각광받고 있습니다.
여성 질 건강 닥터 페미퓨어캡슐 가격에 대해 궁금합니다
- 지금까지 여성 질 건강 닥터 페미퓨어캡슐 성분 및 효능에 대해 자세히 알아보았으며, 가격에 대해 궁금해하실 수 있습니다.
- 닥터 페미퓨어캡슐 가격은 캡슐 당 180mg, 30캡슐 한 박스 기준으로 온라인 홈페이지에서 5만원 중반대에 판매되고 있습니다.

- 다만, 이러한 프로바이오틱스 유산균 제품의 경우, 단순히 가격만 고려하는 것이 아닌, 핵심성분 종류(균주) 및 함량(CFU)를 고려하여야 합니다.
- 흔히, 20억, 50억, 100억 유산균(CFU) 표시가 함량을 의미하며, 또한 위산 및 담즙으로부터 사멸률을 최소화한 공정과정을 확인할 필요 있습니다.
- 무엇보다도, 직접 복용 및 부모님 선물용 등의 구매 목적에 따른 캡슐 및 분말 가루 등의 복용법부터 효능에 관여하는 부가적인 성분을 감안하여야 합니다.
- 이러한 과정이 나이가 있는 중년 분들에게 다소 번거롭고 복잡하게 느낄 수 있으나, 사실 찾아보시면 꼭, 오늘 이야기한 제품이 아니더라도,
- 지난 든실이네 건강 data 카테고리에서 별도의 포스트로 자세히 이야기 나누었듯이, 다이어트 유산균, 드시모네, 갱년기 유산균 YT1, 등 다양한 제품이 시중에 존재합니다.
- 따라서, 앞서 이야기한 기준에 입각하여, 각 제품의 홈페이지를 통해 실질적인 성분 및 공정과정, 가격을 비교 후에 최종적으로 구매하는 것이 현명합니다.
정리
- 과거에는 유산균이 어린이부터 나이가 있는 중년 및 고령자분들까지 장 건강 개선으로 하여금 면역력 증진에 초점을 두는 경우가 많았습니다.
- 하지만, 최근 몇 년전부터 균주에 대한 특허 및 연구개발이 진행되면서 오늘의 주제처럼 면역력 증진뿐만 아니라,
- 다이어트에 관여하는 유산균부터 여성의 질 건강 및 갱년기 증상 예방에 효능이 존재하는 프로바이오틱스 유산균 제품이 선호되고 있다는 점을 본문을 통해 자세히 숙지할 수 있었습니다.
- 앞서 제품 기준 이야기할 때 잠시 언급했듯이, 다양한 각기 다른 균주에 따른 다양한 유산균에 대해 든실이네 건강 data 카테고리에서 이야기 나누었던 적이 존재합니다.
- 따라서, 이번 글을 읽고 면역력 증진뿐만 아니라 다이어트, 질 건강, 갱년기 증상 예방 효능에 목적을 두고 있는 경우,
- 든실이네 데이터 하우스 상단의 검색 기능을 이용하시거나, 아래의 글을 참고하시면 유산균을 이해하고 제품 비교에 도움이 되는 점 참고하셨으면 하는 바람입니다.
프롤린 유산균 가루파는곳 및 효능부터 가루가격 정리
오늘은 든실이네 39번째 건강 이야기 "프롤린 유산균" 관하여 설명을 드리고자 합니다. 지상파 프로그램에서 어느 방송인이 고도 비만에서 25kg 감량하면서 화제가된 바 있습니다 이날 방송에
deunsil.tistory.com

이번 포스트에서는 여성 질 건강 유산균 닥터 페미퓨어캡슐 성분 및 효능부터 가격에 대해 자세히 정리하는 시간을 가져보았습니다. 꼭 전달하고자 하는 내용을 글로 작성하다보니 글이 다소 길어졌으나 서론부터 천천히 정독하는 경우, 나이가 있는 중년 분들도 이해하는 데 큰 어려움은 없을 것으로 판단이 됩니다. 이번 내용을 통해 또 하나의 영양제 지식이 쌓였으며, 근본적인 면역력 개선부터 더 나아가, 여성 질 건강 및 갱년기 증상 예방에 조금이나마 도움이 되었으면 하는 바람입니다. 지금까지 든실이 이었으며, 오늘도 에너지가 솟구치는 건강한 하루 되십시오.
'건강 data > 영양과 효능' 카테고리의 다른 글
| 트루락 황후의 유산균 성분 및 효능부터 가격 정리 (0) | 2021.03.02 |
|---|---|
| 명품 참당귀 데커신 골드 추출 분말 가루 효능 및 성분부터 가격 정리 (0) | 2021.03.02 |
| 리스펙타 지노마스터 질 건강 유산균 효능 및 성분부터 가격 정리 (0) | 2021.03.02 |
| 셀트리온 면역엔 N 포스트바이오틱스 유산균 효능 및 가격 정리 (0) | 2021.03.02 |